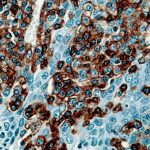

|
|---|
 Anti-CD43 (T Cell, Leukosialin) Anti-CD43 (T Cell, Leukosialin)Buy here |
 Anti-CD44 (Phagocytic Glycoprotein-1, HCAM) Anti-CD44 (Phagocytic Glycoprotein-1, HCAM)Buy here |
 Anti-CD45 Anti-CD45Buy here |
 Anti-CD45 (Leukocyte common Antigen, LCA) Anti-CD45 (Leukocyte common Antigen, LCA)Buy here |
 Anti-CD45 (Leukocyte common Antigen, LCA) Anti-CD45 (Leukocyte common Antigen, LCA)Buy here |
 Anti-CD45 Cocktail (Leukocyte Antigen, LCA) Anti-CD45 Cocktail (Leukocyte Antigen, LCA)Buy here |
 Anti-CD45RA Anti-CD45RABuy here |
 Anti-CD45RC (T Cell) Anti-CD45RC (T Cell)Buy here |
 Anti-CD45RO (T Cell) Anti-CD45RO (T Cell)Buy here |
 Anti-CD47 Anti-CD47Buy here |